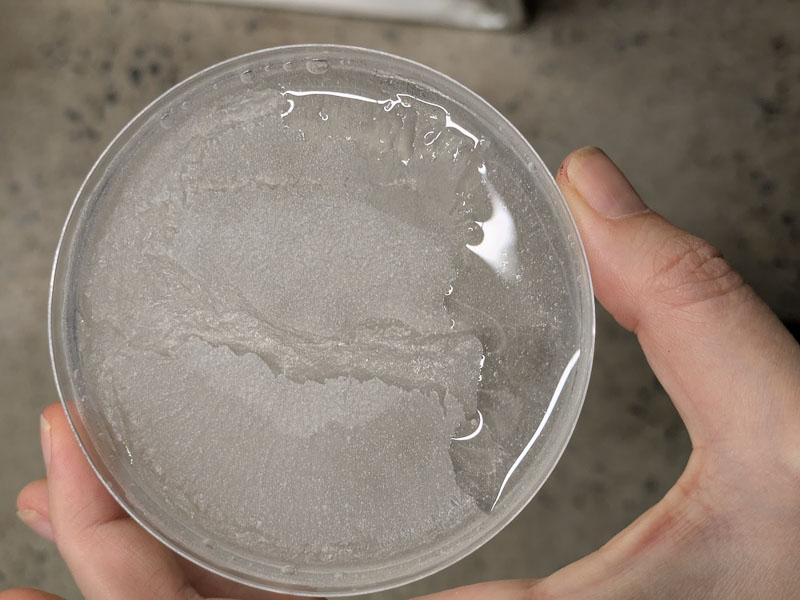

10. Textile Scaffold¶
Research¶
As a maker, I love the idea of letting nature do it's thing instead of telling it what I want it to be - studying its tendencies and leaning into them - guiding it gently but letting it do most of the work.
Years ago I'd seen the work of Gavin and Alice Munro and it left a big impression on me. Gavin and Alice graft their own chairs out of vines. It can take more than a decade to create a single chair! But the results are so much fun.
Here you can find the full article: Full-grown Furniture Trees (CNN)
In architecture this process is called baubotanik and it's the process of using plant growth the create joints and stabilize a structure. As it pertains to our lecture, I suppose the tree is the matrix and the pipes added are the support or reinforcement. The term was coined by Dr. Ferdinand Ludwig, a professor at the Technical University of Munich. So this is the first place my mind went as we discussed scaffold in the lecture this week.
Baubotanik – Living Tree Article
It didn't have a big hand in what I did this week but I'd love to explore this concept more and thought it was a cool reference people should know about.
References & Inspiration¶
As far as work that did help me this week I really enjoyed the previous projects of Fabricademy alumni Elsa Gil. Elsa worked with crystals and explains the properties of crystal growing nicely:
Textile as Scaffold — Elsa Gil
This video by Liam Riggs on Youtube was also a nice overview:
And I also used the previous tutorial off Petra Garajova from 2022/23.
Process and workflow¶
I started with crystals. Annie and I talked about how crystals form. When water is cold it is more dense than when it is warm. It's molecules move closer together. When it's hot they spread further apart. So if you were to add something soluble to the water, like salt, there is more space for the salt to fit in hot water. As it cools the molecules move closer again. So in theory - the salt won't have any more space to go and instead of dissolving it will form crystals.
Drawing of molecules in hot vs. cold water © Claire Cavanagh, Fabricademy, 2025
Crystal Steps¶
Epsom Salt
So for my first experiment we did two opposite things with Epsom salt. The first operated on the principle of water evaporation to make crystals:
⦁ First I cleaned all my jars and utensils.
© Claire Cavanagh, Fabricademy, 2025
⦁ Then I started with 500ml of water in a jar and added Epsom salt until it reached the saturation point at room temperature.
-
Unfortunately I lost my recording of the exact amount, but it was about x6 full 16oz mason jars of salt.
-
As we added salt, the volume of liquid began to grow because the salt was taking up more space. So we separated this salt water into three new jars.
⦁ The first two had 250mls of water each.
⦁ They went in the dehydrator which we left at 35 degrees Celsius for 24 hours.
- (one had a lining of plastic held with an elastic to see if the crystals adhered to its catenary-like shape. The second was a regular plastic container.
The third jar was used to test the principle of going from hot to cool:
⦁ We took this solution and added around 1/4 cup more water and re-heated it up in the microwave.
⦁ This went into a long narrow jar where we added a piece of synthetic mesh-like fabric that had some airflow.
⦁ We tried to glue crystals on it so more would be apt to stick. We left this jar out at room temperature.
Mesh fabric in jar to be filled with crystal solution © Claire Cavanagh, Fabricademy, 2025
After 24hrs film like crystals had indeed started forming on the bottoms of my dehydrator containers. It also started floating on the top.
Crystals on the bottom of my dehydrator container © Claire Cavanagh, Fabricademy, 2025
I left these crystals where they were and let the solution keep dehydrating for another 8hrs.
My long strip of fabric also had a light dusting of crystals where the water line touched the air. It has also stiffened under the water with an evern lighter layer of crystals but they were very hard to see.
(video of long strip)
I took it out of the jar and hung it to dry.
For my next crystal experiments I tried Suspending elements in a jar on a string.
I also did one test with salt lines that I left on the bottom of a plastic container as you can see in the image below.
I used Alum and Epsom salt respectively. For both I used a ratio of:
⦁ 1000ml of water to 300g alum/ salt
(that's 500ml to 150g of powder)
⦁ I filtered my solutions with a coffee filter and separated it in various jars.
Alum experiments © Claire Cavanagh, Fabricademy, 2025
These ones were alum:
Alum salt lines on sticky paper, seperated by tape and left at bottom of plastic container © Claire Cavanagh, Fabricademy, 2025
Alum ball to be suspended in synthetic mesh © Claire Cavanagh, Fabricademy, 2025
Hot Glue Grid © Claire Cavanagh, Fabricademy, 2025
Hardened milkweed-alginate-glycerin strings © Claire Cavanagh, Fabricademy, 2025
These ones were Epsom salt:
Abstract glue shape © Claire Cavanagh, Fabricademy, 2025
Suspended milkweed pod © Claire Cavanagh, Fabricademy, 2025
I also put the last of my solution in a few petri dishes and stuck them in the dehydrator.
This time I turned it up to 45 degrees Celsius for 18hrs.
In the morning not much had happened to any of my suspended elements. The milkweed pod was the only test that seemed to have a few small crystals growing.
Submerged milkweed pod with crystals growing © Claire Cavanagh, Fabricademy, 2025
The dehydrator petri dishes however did have a film growing - just like the initial plastic container tests. I left them all to continue evaporating in the dehydrator for another 8 hrs.
Crystals dish 1 © Claire Cavanagh, Fabricademy, 2025
Crystals dish 2 © Claire Cavanagh, Fabricademy, 2025
Crystals dish 3 © Claire Cavanagh, Fabricademy, 2025
In summary I think I will continue playing with my ratios of salt to water. I found I needed a much higher ratio of salt to water than Petra's suggestion of 60g of alum to 500ml of water in order to start seeing the salt stop dissolving. In none of my tests did I feel like I truly hit the solubility point because over time the salt always just kept dissolving. It just disolved slower and slower. It might have had more to do with the speed of the water cooling too. More tests are needed to isolate the most likely factor.
Three weeks later...
This is the result of my Milkweed crystalization. It ended up forming a really nice dusting of crystals. The top got a bit mouldy - but I ended up with this two tone affect.
Milkwood pod crystals © Claire Cavanagh, Fabricademy, 2025
Milkweed pod crystals © Claire Cavanagh, Fabricademy, 2025
This is the result of my crystal mesh fabrics.
Mesh fabric crystals © Claire Cavanagh, Fabricademy, 2025
And I acutally did start to get one big crystal in the bottom of my container!! It took a long time but I'm very happy. Just be prepared for it to take a while if you are leaving it out for the water to evaportate.
Big crystal and plastic jar © Claire Cavanagh, Fabricademy, 2025
Biomaterial Steps¶
For my next "scaffold" tests I went back to my old friend Sodium Alginate + Glycerin.
I wanted to experiment with creating a mould like Miguel Fisac's work with concrete techniques using string and concrete casting. Only I would use my biomaterail mixture.
The idea being that when my solution was poured over my fabric/string frame, the taught strings would imprint upon it, whereas the solution sitting on the stretch material would sag between the cracks.
So I made a frame using fishing line, and nails. I did a truckers hitch knot which was the best for securing the fishing line since it's slippery.
Mould Frame with fishing line © Claire Cavanagh, Fabricademy, 2025
Stretch materials attached to frame © Claire Cavanagh, Fabricademy, 2025
I also pulled a bunch of wood offcuts from the trash that someone had used for a different project. They were interesting shapes so I used them as additional moulds as you will see below.
Ingredients & Recipes¶
My base recipe was as follows:
- 12g alginate
- 30 g glycerin
- 400ml water
I ultimately doubled this recipe so I could do more tests.
Plus
Hardening solution:
- 10ml of Calcium Chloride
- 100ml water
MILKWEED FLOSS:
I blended the milkweed floss thoroughly in a food processor until it appeared that it wasn't blending anymore.
I called this Test C
- 2.07 g Milk week floss
- 251.64g alginate-glycerin
Dry milkweed floss © Claire Cavanagh, Fabricademy, 2025
Alginate-Glycerin © Claire Cavanagh, Fabricademy, 2025
COFFEE:
This was my medium particle test. I wanted to see how much the coffee reinforced the solution.
Test 1
- 1 tbsp of Coffee grinds
- 20g of alginate-glycerin solution
Coffee Grinds © Claire Cavanagh, Fabricademy, 2025
Test 2
- 1tbsp coffee
- 40g of alginate-glycerin solution
Test 3
- 1tbsp coffee
- 60g of alginate-glycerin solution
Test 4
- 1 tbsp coffee
- 80g of alginate-glycerin solution
CARBON:
This was my small particle test. I wanted to see how much small particles reinforced the solution.
Test A
- 1 tbsp carbon powder
- 15g alginate glycerin
Test B
- 2 1tbsp carbon powder
- 120g alginate-glycerin
SUMAC:
Test D
This was my Big Particles test. I has to eyeball the rations here because I was more focused on the colour/ finish. I wanted to turn these ones into Christmas ornaments. I only had a small amount of my "matrix" aka alginate-glycerin left so I added the sumac "to taste" based on the colour saturation (which changed as it blended).
NOTCHES
I called these tests "Notches" because the moulds I was interested in had little notches in them. When they dry I'd like to see if I can slot these pieces together for further reinforcement and 3d play. I also had left over soltuion, but I still labelled it "notches" even though some were different shapes (sans notches).
For the Notches, my base recipe was:
- 12g alginate
- 400ml water
- Zero glycerin
Plus
- Hardening solution:
- 10ml of Calcium Chloride
- 100ml water
Notch Moulds with pine needle reinforcement and carbon © Claire Cavanagh, Fabricademy, 2025
NA
- 1 tbsp pine needles
- 2 tbps alginate
NB
- 1 tps carbon
- 1tbsp alginate
NC
- 1tbsp carbon
- 2 tbsp alginate
Milkweed solution Test C, in string mould |
Coffee Test 1 in string mould |
Coffee Tests 1 through 4 |
Carbon Test B example |
Excess biomaterial tests © Claire Cavanagh, Fabricademy, 2025
All the tests © Claire Cavanagh, Fabricademy, 2025
RESULTS¶
Scaffold Test
COFFEE:
Test 1
-
Texture:
-
Rough to the touch
-
Strength:
-
Strong, dense and hard
-
thickest sample
-
Pliability:
-
Not pliable at all
-
will break if bent, but also hard to bend
Test 2
-
Texture:
-
Rough to the touch
-
Strength:
-
Less dense than Test 1, but still very hard
-
Pliability:
-
Not pliable
Test 3
-
Texture:
-
Rough to the touch
-
Strength:
-
Strong
-
Same density as Test 2
-
Pliability:
-
slightly pliable, but reaches snapping point quickly
Test 4
-
Texture:
-
Rough to the touch
-
Strength:
-
The least dense
-
Tears more easily than other samples but does not snap as easily, so in some ways more durable that tests 1-3 depending on the project.
-
Pliability:
-
Pliable, and almost completely foldabale. Could possibly be used for more foldable projects but even more alignate-glycerin solution is recommened.
Summary: The coffee tests turned out much harder and dryer than I expected after leaving them over the weekend. The water felt completely absorbed except in Test 4, which was the most malleable. They all also shrunk and curled signifiantly at room temprature over a couple of days. But they did not flake and felt very well bonded in all samples.
CARBON:
Test A
-
Texture:
-
Rough to the touch
-
Very dry, but did not automatically leave carbon on hands unless rubbed hard
-
Even surface, did not curl
-
Strength:
-
Very well bonded
-
Very dense
-
Pliability:
-
Not plibale at all.
Test B
-
Texture:
-
Rough to the touch
-
very dry, but did not automatically leave carbon on hands unless rubbed hard
-
curled drastically over the weekend at room temperature
-
Strength:
-
Well bonded
-
Less dense than test B
-
Pliability:
-
Slightly pliable,
Summary:
Overall I loved these tests. The samples are very lightweight and not nearly as messy as I expected them to be. The carbon is very well bonded and they absorbed the mosture very well. As a result the more vicous solution curled drastically but Test A, with only 15g or algiante-glycerin cured nice and flat.
SUMAC:
Test D
-
Texture:
-
Slightly bumpy
-
Seeds became smoother and less fuzzy
-
Strength:
-
Soft and malleable but tearable
-
Pliability:
-
very bendable
Summary:
All of my sumac seeds liked to find eachother and clump together. In all my tests the migrated closer to the centre, leaving more transparents areas of just alginate-glycerin near the top.
NOTCHES
N-A - Pine Needles
-
Texture:
-
slightly rough,
-
flaky
-
Strength:
-
Very light-weight and solid
-
Pliability:
-
Not bendable at all
N-B - Carbon
-
Texture:
-
Very crumbly
-
Strength:
-
not very strong, crumbles easily
-
Pliability:
-
Not bendable at all
N-C Milkeweed Floss
-
Texture:
-
Smooth, silky and plastic-like
-
Strength:
-
Very light weight.
-
tearable but not snappable
-
Pliability:
-
Very pliable for a cylinder shape, but not totally foldable or creaseable.
Summary:
I loved how the milkweekd tests turned out. They became much more yellow over time. They are a really interesting finish - shiny and smooth and a little transparent.
Table Summary¶
Again the base recipe for my milkweed, coffee and sumac tests was as follows:
-
12g alginate
-
30 g glycerin
-
400ml water
| Material pic | Material name | polymer | plastisizer | filler | emulsifier |
|---|---|---|---|---|---|
![]() |
Test C - Milkweed Floss | 251.6g Base Recipe | 30 g glycerin | 2.07g milkweed floss | Calcium Chloride 10g, Water 100ml |
| Material pic | Material name | polymer | plastisizer | filler | emulsifier |
|---|---|---|---|---|---|
![]() |
Test 1 - Coffee | 20g Base Recipe | 30 g glycerin | 1 tbsp of Coffee grinds | Calcium Chloride 10g, Water 100ml |
| Material pic | Material name | polymer | plastisizer | filler | emulsifier |
|---|---|---|---|---|---|
![]() |
Test 2 - Coffee | 40g Base Recipe | 30 g glycerin | 1 tbsp of Coffee grinds | Calcium Chloride 10g, Water 100ml |
| Material pic | Material name | polymer | plastisizer | filler | emulsifier |
|---|---|---|---|---|---|
![]() |
Test 3 - Coffee | 60g Base Recipe | 30 g glycerin | 1 tbsp of Coffee grinds | Calcium Chloride 10g, Water 100ml |
| Material pic | Material name | polymer | plastisizer | filler | emulsifier |
|---|---|---|---|---|---|
![]() |
Test 4 - Coffee | 80g Base Recipe | 30 g glycerin | 1 tbsp of Coffee grinds | Calcium Chloride 10g, Water 100ml |
| Material pic | Material name | polymer | plastisizer | filler | emulsifier |
|---|---|---|---|---|---|
![]() |
Test A - Carbon | 15g Base Recipe | 30 g glycerin | 1tbs Carbon powder | Calcium Chloride 10g, Water 100ml |
| Material pic | Material name | polymer | plastisizer | filler | emulsifier |
|---|---|---|---|---|---|
![]() |
Test B - Carbon | 120g Base Recipe | 30 g glycerin | 2 tbs Carbon powder | Calcium Chloride 10g, Water 100ml |
| Material pic | Material name | polymer | plastisizer | filler | emulsifier |
|---|---|---|---|---|---|
![]() |
Test D - Sumac | Base Recipe (free pour) | 30 g glycerin | Sumac to "taste" | Calcium Chloride 10g, Water 100ml |
Again the base recipe for my Notches tests was as follows:
-
12g alginate
-
400ml water
-
Zero glycerin
| Material pic | Material name | polymer | plastisizer | filler | emulsifier |
|---|---|---|---|---|---|
![]() |
NA - Pine Needles | 2 tbps Base Recipe | Zero glycerin | 1tbsp Pine Needles | Calcium Chloride 10g, Water 100ml |
| Material pic | Material name | polymer | plastisizer | filler | emulsifier |
|---|---|---|---|---|---|
![]() |
NB- Carbon | 1 tbps Base Recipe | Zero glycerin | 1 tbsp Carbon Powder | Calcium Chloride 10g, Water 100ml |
| Material pic | Material name | polymer | plastisizer | filler | emulsifier |
|---|---|---|---|---|---|
![]() |
NC - Carbon | 2 tbps Base Recipe | Zero glycerin | 1tbsp Carbon Powder | Milkweed |